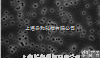
JCWP09025  OMNIPORE（亲水性PTEF）表面<em>滤膜</em> 10um孔径，<em>90mm</em>直径

90mm滤膜保存盒
- 供应商:北京莱德凯斯科技有限公司
- 供应商报价:面议
- 标签:90mm滤膜保存盒,3.7,北京莱德凯斯科技有限公司
滤膜保存盒是专门针对大气颗粒物采样,单张滤膜单独存放的要求设计的。避免了以往采样滤膜存放在铝箔纸袋、塑料袋、折叠夹等方式造成的滤膜上的颗粒物丢失、滤膜变形、样品污染等问题。
滤膜保存盒:用于保存、运送滤膜,保证滤膜在采样前处于平整不受折状态。
Φ47mm滤膜盒,适合≤47mm的滤膜。
Φ90mm滤膜盒,适合≤90mm的滤膜。
产品特点
1,滤膜盒盖内带有压环,能固定住滤膜,避免滤膜移动,丢失样品;
2,由性能稳定的材质制成,不会对采集到颗粒物的滤膜有任何污染;
3,底端边沿设有取膜口,方便取、放滤膜;
4,滤膜盒可以灭菌,可以清洗后重复使用(Z好用环氧乙烷灭菌,射线灭菌,不要超过50度);
5,滤膜盒原材料聚苯乙烯,惰性材料对滤膜不粘连,方便取放。
使用方法
1,请佩戴实验室专用手套;
2,小心打开滤膜盒;
3,请拿起平头镊子;
4,对于47mm/90mm的滤膜可以直接放入滤膜盒中,并盖上圆形上盖即可;
6,贴上书写标签,做好采样纪录。